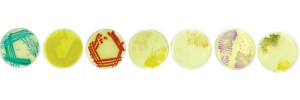

Microbes captured in living display
Seven different bacteria and several yeasts and fungi which are commonly found all around us – and even inside our guts - were used to create a living microbial display, on show in a glass cabinet in the foyer of the JC Smuts building at Stellenbosch University until this Friday only.
“This is a unique opportunity to get a glimpse of the rich diversity of microbes in and around us, captured together in one display," explains Dr Heinrich Volschenk, part of the team of staff and students in the Department of Microbiology who planned and executed this unique example of microbial art.
Taking some inspiration from the creators of the bacterial billboard for the movie Contagion, the microbes were selected specifically for their bright colours and safety. The raison-d'être for the display is, of course, to celebrate the University's centenary.
Thus far, the microbes have surpassed all expectations.
“Because of the cold weather, they are growing slower than expected. But now the different colours are more evident, as well as the different morphologies," says Mrs Trudy Jansen, also from the Department of Microbiology.
You will, for example, now be able to recognise the smelly green mould that forms on that orange which has been lying forgotten at the bottom of your bag. Or the blueish, grayish mouldy stuff on last week's sandwiches.
If you look really closely, while holding up your breath long enough, you will also be able to observe the traces of microscopic small mites which have since colonised the display cabinet: “They are in the air all around, but we cannot see them. Now we can observe how they have appeared out of thin air to feed on the abundance of food available," Jansen comments.
On social media, fellow microbiologists simply can't wait for the next update: “It is 24 hours later – our super reliable Serratia is growing like crazy. Some fluorescent green Pseudomonas coming through, and numerous orange and pink yeasts starting to show up. By tomorrow the yellow Micrococcus luteus should make its appearance?", wrote Dr Shelly Dean in a Facebook post. There were also daily updates on Twitter from @volschenk:
And for a video to see how this display came about, visit https://www.facebook.com/stellenboschuniversity/videos/699363127110615/
On the photo below, the microbial art team from SU's Department of Microbiology are, from left to right, Odwa Biko, Zoë Bhana, Dr Heinrich Volschenk, Shakier Samie, Lindsay Faure, Ivan Harris, Dr Shelly Deane, Caylin Bosch, Dr Thando Ndlovu, Jane de Kock, Prof. Alf Botha, Trudy Jansen, Wendy Wentzel, Monique Waso, Tersia Conradie, Kathryn Griessel, Warrick Sitzer, and Marisa Valentine. People involved, but not in the photograph: Prof Wesaal Khan, Tania van der Merwe, Méshelle Gey van Pittius, Ludwig Brocker, Alno Carstens and Elzaan Booysen

